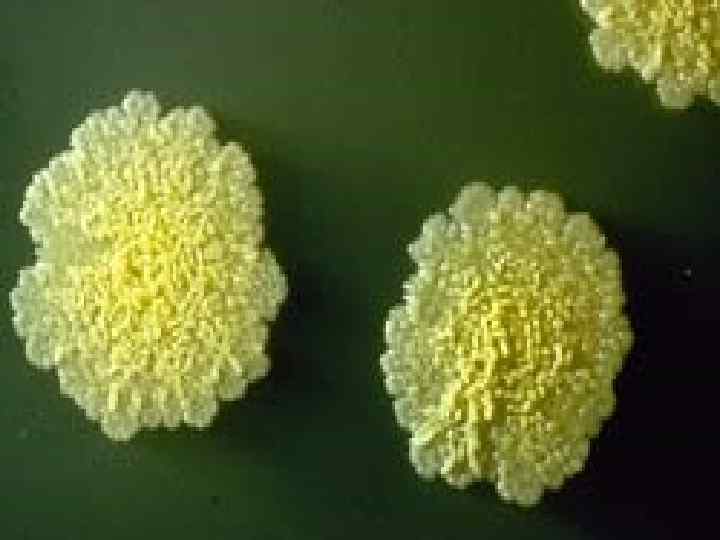

КРУЖОК ТУБ.pptx
- Количество слайдов: 121

тренинг ПО ПРОФИЛАКТИКЕ ТУБЕРКУЛЕЗА «ТУБЕРКУЛЕЗ МОЖНО ПОБЕДИТЬ »


БЕЛАЯ РОМАШКА – СИМВОЛ ЧИСТОГО ДЫХАНИЯ

Туберкулез – грозное заболевание, уносящее жизни тысячи людей



Ежегодно по решению Всемирной Организации Здравоохранения во всех странах мира проводятся мероприятия, в ходе которых специалисты и волонтеры разъясняют людям, как важно знать меры профилактики и борьбы с эпидемией туберкулеза







Роберт Кох


«Если опасность болезни определяется количество жертв, то туберкулез оставит позади себя самые страшные инфекционные заболевания человечества, как бубонная чума и холера» Роберт Кох

Чума



Картина

Ежегодно в мире туберкулез поражает около восьми миллионов человек, умирает – три миллиона

Инфицирована примерно треть населения Земли

Примерно каждую секунду возникает новый случай инфекции

• США

Европейцов



За прошедшие годы в Казахстане произошла существенная стабилизация эпидемиологической ситуации по туберкулезу


Регионами с высоким числом инфицированных палочкой Коха остаются: Актюбинская, Атырауская, Западно Казахстанская, Кызылординская, Мангистауская области.



Западно-Казахстанская область





Новая тенденция в эволюции туберкулеза: растет устойчивость возбудителей болезни к лекарствам. Такая проблема наблюдается в 24 % случаев.


В социальном плане: 1. Медперсонал не проявляет должного уважения и внимания к больным


2. Сами больные в 50 % случаев прерывают лечение

3. Население из за своей низкой осведомленности не занимается профилактикой


Проблема туберкулеза зиждется на трех буквах «Б»

Бедность

Безразличие

Безграмотность

Роберт Кох: «Остановить его (туберкулеза) рост и распространение можно только тогда, когда каждый человек будет хорошо знать и применять свои знания по профилактике туберкулеза в повседневной жизни»

«Живая диаграмма»

Ø Туберкулез – это инфекционное заболевание Ø Туберкулез социальное заболевание Ø Возбудителем заболевания является палочка Коха Ø Наиболее частый путь передачи от матери к плоду Ø Солнечный свет на туберкулезную палочку действует благотворно Ø Туберкулез передается через мясо и молоко зараженных животных Ø Один из ранних признаков туберкулеза – это кашель более трех недель Ø Флюорографию проходят с целью выявления туберкулеза

Ø Лечение туберкулеза в Казахстане бесплатно Ø 10. Флюорографию проходят 2 раза в год Ø 11. От туберкулеза полностью излечиться можно Ø 12. Туберкулезом подростку легче всего заразиться в многолюдных местах Ø 13. Больные алкоголизмом или наркоманией подвергаются повышенной опасности заражения туберкулезом Ø 14. Взятие мокроты на туберкулез основной метод диагностики туберку леза Ø Лечение туберкулеза проводится по системе ДОТС


При комнатной температуре сохраняет жизнестойкость в течении 2 -10 месяцев




Самая низкая температура , которую выдерживает туберкулезная палочка – 280 гр. !

На солнечном свету погибает Через 1, 5 -2 часа

При ультрафиолетовом облучении и кипячении за 5 -10 мин

29% детей – курят, каждые третий из них курит постоянно; в последние 4 года пьянство среди подростков возросло в 2, 5 раза; 5000 подростков в Казахстане имеют отклонения в психофизическом развитии


Провоцирующие факторы: Ø простудные заболевания, Ø вредности на работе(сквозняки, холод), Ø психические и физические травмы Øособое значение имеет и контакт с туберкулезным больным

Особое значение имеет иконтакт с туберкулезным больным • КАРТИНКА

Угрозой заболевания является употреблние в пищу мяса и молока больных туберкулезом животных

.

РЕКОМЕНДУЕТСЯ: ü не листать книги смоченным в слюне пальцем, т. к. туберкулезная полочка сохраняется на страницах книги 2 3 месяца; ü не пить напитки из одной бутылки и другой посуды, т. к. попав в воду, туберкулезная палочка сохраняется до 5 месяцев; ü не откусывать от одного куска, иметь при себе индивидуальную емкость для питья

üмыть руки после посещения туалетов, перед приемом пищи, используя индивидуальные средства для вытирания рук, üизбегать переохлаждения, üследить за чистотой обуви, т. к. в пыли и на одежде туберкулезная палочка может сохраняться до 3 месяцев

Игра “спорные утверждения”

ИГРА «СПОРНЫЕ УТВЕРЖДЕНИЯ» Ø Туберкулез –это инфекционное заболевание: Ø Туберкулезом легче заразиться, если в семье уже есть больной туберкулезом Ø Заражение туберкулезом возможно при кратковременном контакте с туберкулезным больным Ø Ребенок может заразиться туберкулезом от больной матери через грудное молоко Ø Повышенной опасности заражения туберкулезом подвергаются Ø Туберкулез – это социально медицинская проблема Ø Как действует на туберкулезную палочку солнечный свет, ультрафиолетовые лучи? Ø У вас возникло подозрение, что вы заболели туберкулезом. Ваши действия? Ø Лечение туберкулеза в Казахстане бесплатное

Ø Для чего проходят флюорографию Ø Больной, переболевший туберкулезом, больше не подвергается риску повторного заражения Ø Если через 3 месяца состояние больного клинически улучшилось – лечение можно прекратить Ø Вакцинация против туберкулеза способствует снижению риска заболеваемости туберкулезом Ø От туберкулеза можно полностью излечиться Ø Медицинские работники могут заразиться туберкулезом от больных в случае несоблюдения правил защиты


ЕСЛИ Я ГОРЕТЬ НЕ БУДУ?

ЕСЛИ ТЫ ГОРЕТЬ НЕ БУДЕШЬ?

ЕСЛИ МЫ ГОРЕТЬ НЕ БУДЕМ? КТО ЖЕ ЗДЕСЬ РАССЕЕТ ТЬМУ? Н. Хикмет

КРУЖОК ТУБ.pptx